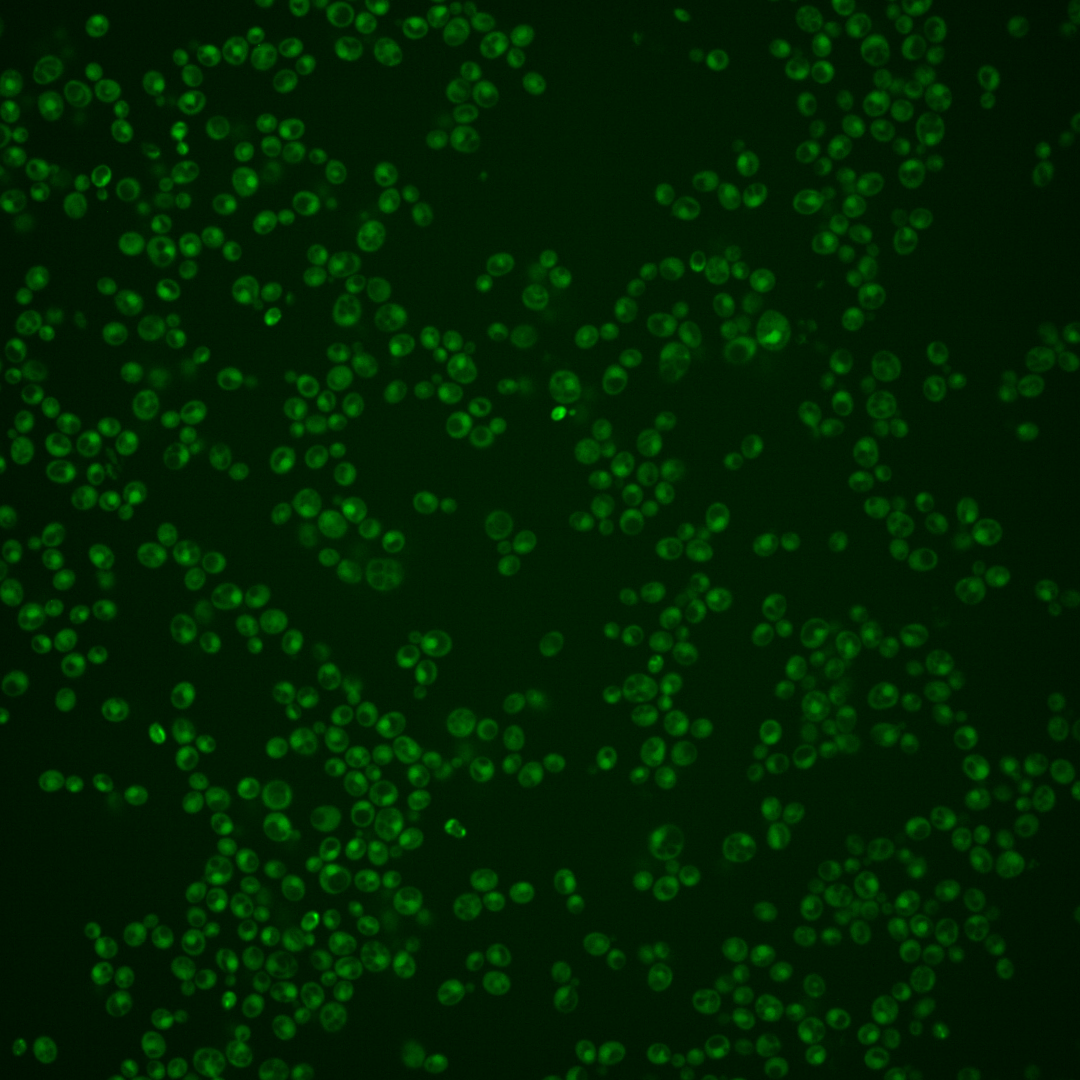
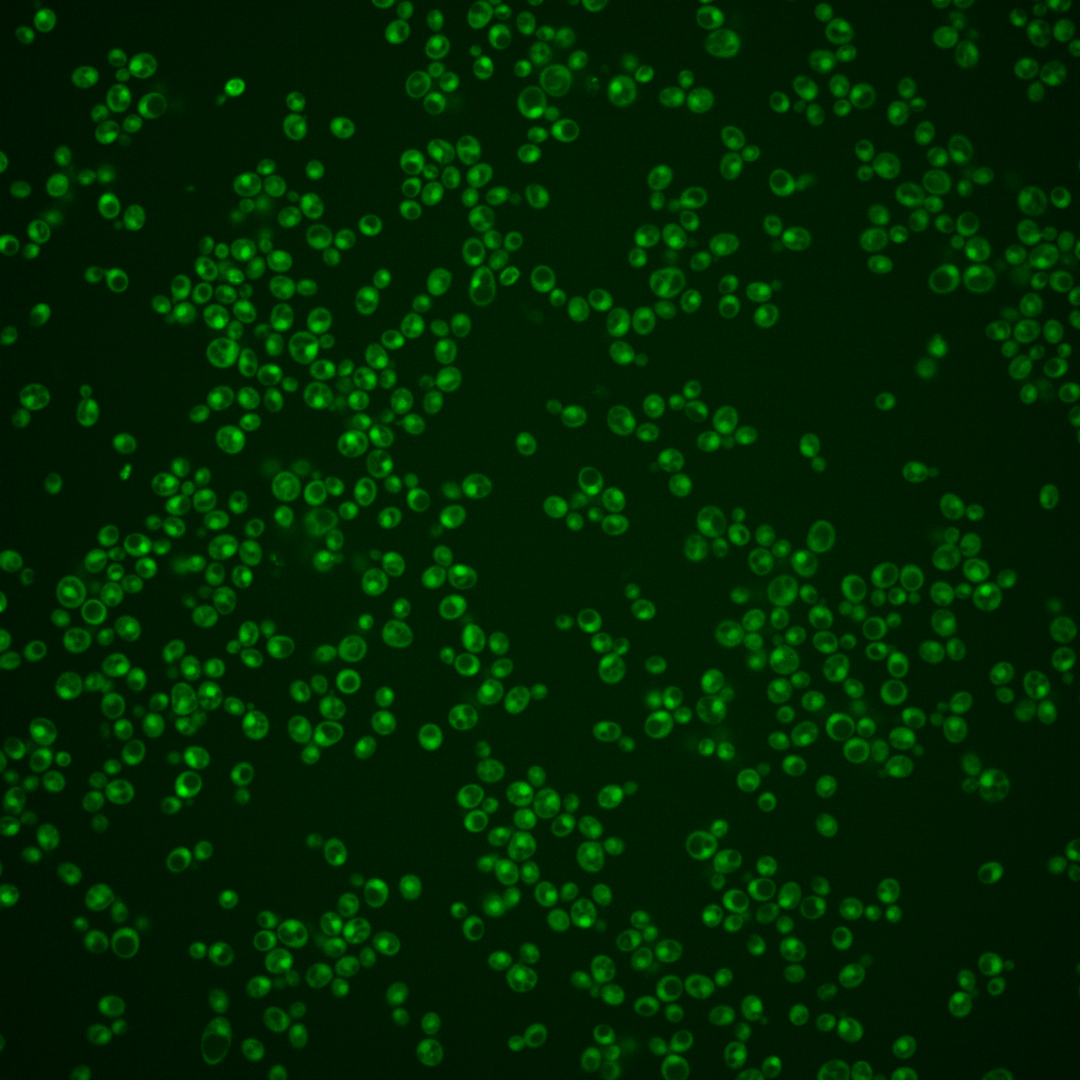
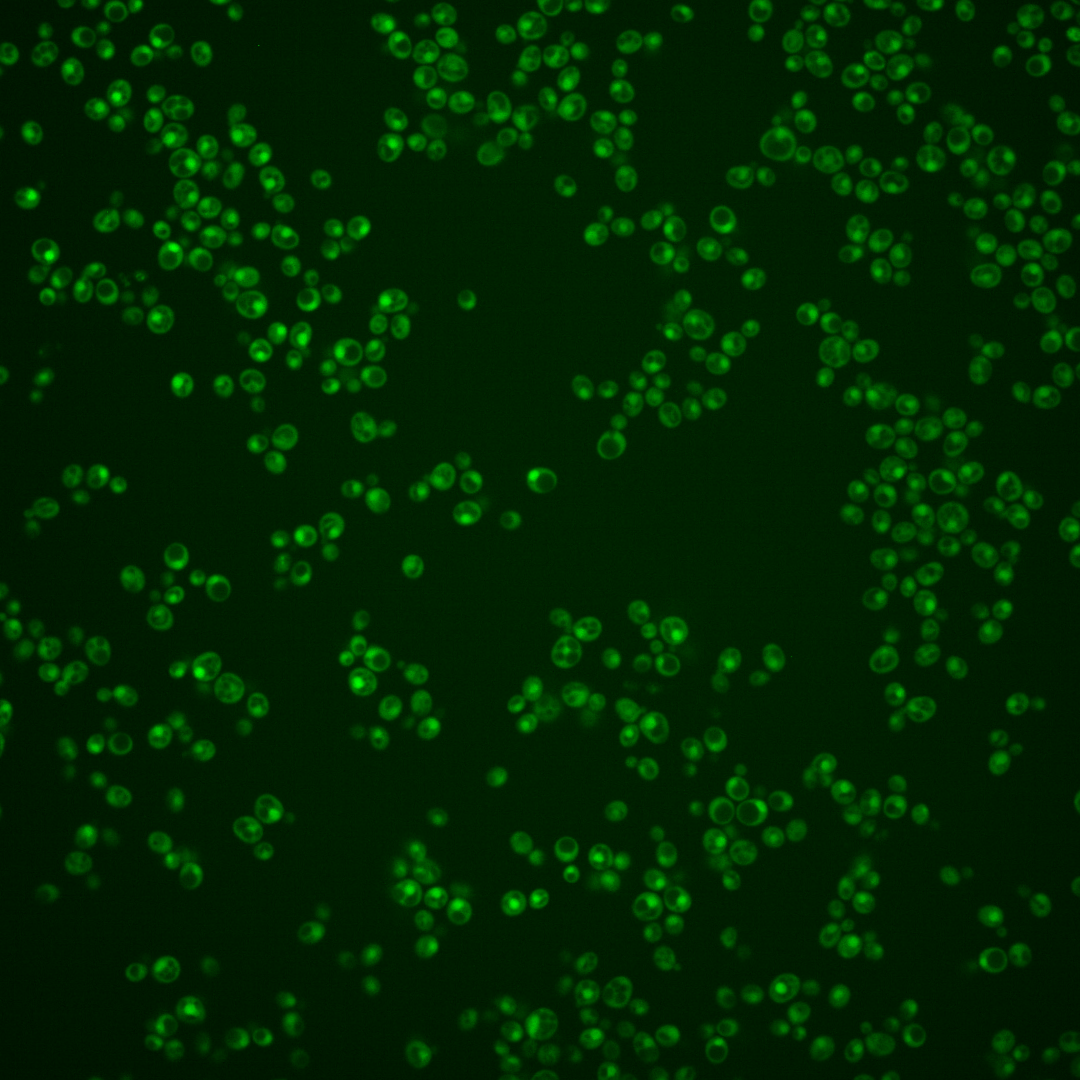
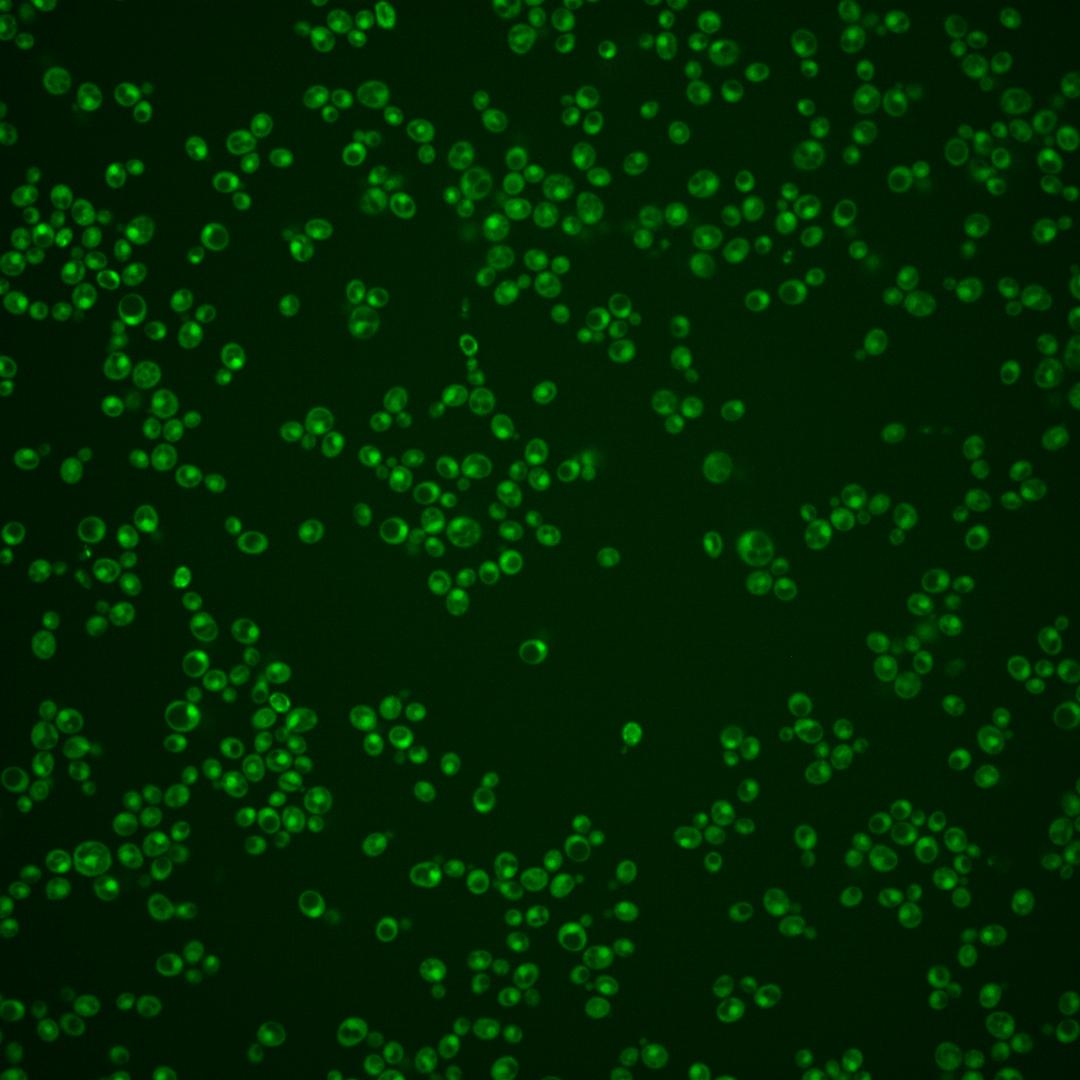
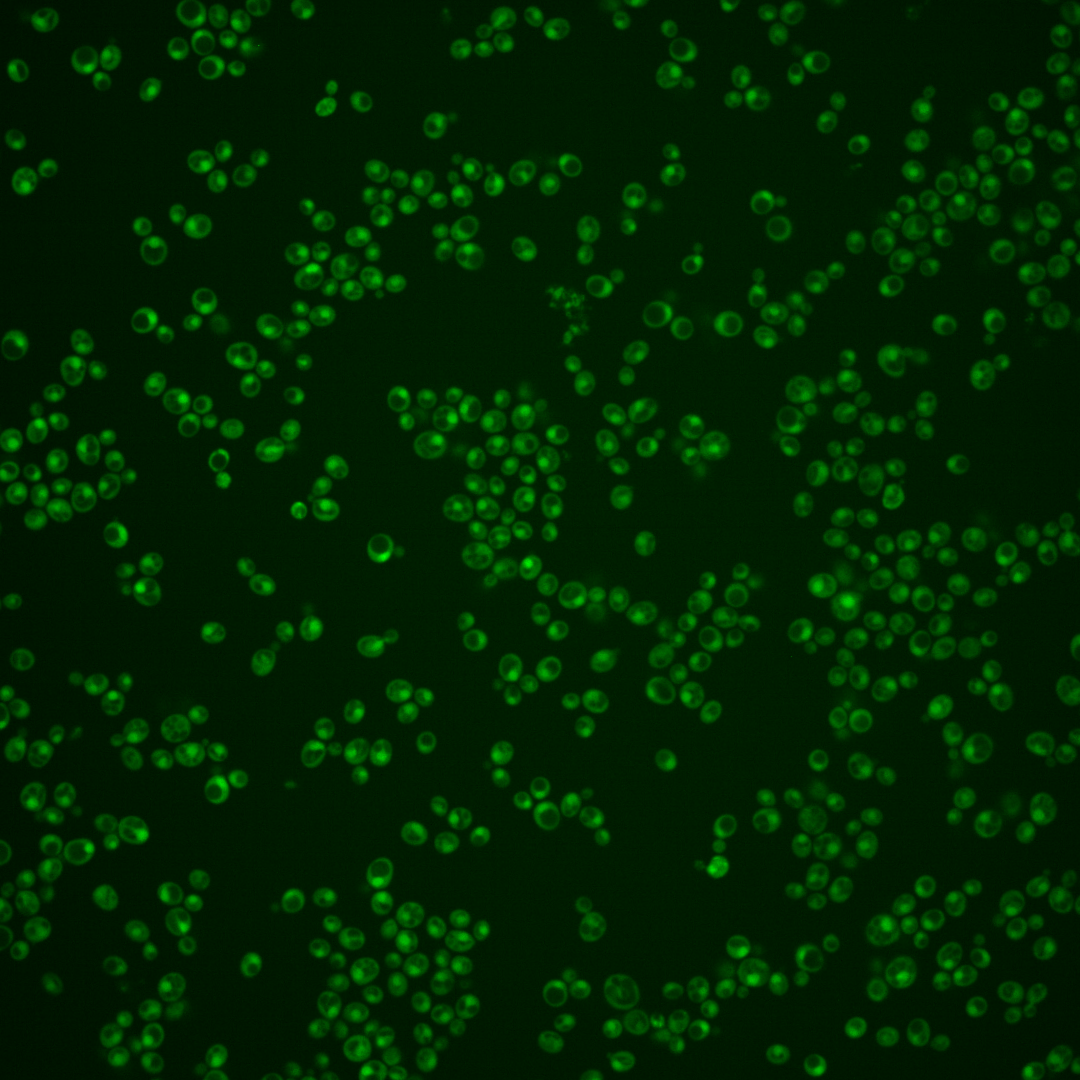

| Standard name | |
|---|---|
| Human Ortholog | |
| Description | SET-domain lysine-N-methyltransferase; catalyzes the formation of dimethyllysine residues on the large ribosomal subunit proteins L23 (Rpl23Ap and Rpl23Bp) and monomethyllysine residues on L18 (Rps18Ap and Rps18Bp) |
Micrographs




















































































Sub-cellular Localization
Yeast GFP Assignment
Protein Abundance
Localization Change
External localization resources
| ensLOC | DeepLoc | |||||||||||||||||||||||
|---|---|---|---|---|---|---|---|---|---|---|---|---|---|---|---|---|---|---|---|---|---|---|---|---|
| Localization | WT1 | WT2 | WT3 | RAP60 | RAP140 | RAP220 | RAP300 | RAP380 | RAP460 | RAP540 | RAP620 | RAP700 | HU80 | HU120 | HU160 | rpd3Δ_1 | rpd3Δ_2 | rpd3Δ_3 | WT1 | WT2 | WT3 | AF100 | AF140 | AF180 |
| Cortical Patches | 0 | 0 | 0 | 0 | 0 | 0 | 0 | – | 0 | 0 | 0 | 0 | – | – | 0 | 0 | 0 | 0 | 0 | 0 | 0 | 0 | 0 | 0 |
| Bud | 0 | 0 | 0 | 0 | 0 | 0 | 0 | – | 1 | 1 | 0 | 1 | – | – | 0 | 0 | 1 | 0 | 2 | 8 | 0 | 1 | 2 | 6 |
| Bud Neck | 0 | 0 | 0 | 0 | 0 | 0 | 1 | – | 0 | 1 | 0 | 0 | – | – | 0 | 0 | 0 | 0 | 1 | 0 | 0 | 0 | 0 | 3 |
| Bud Site | 0 | 0 | 0 | 0 | 0 | 0 | 1 | – | 1 | 0 | 4 | 3 | – | – | 0 | 0 | 0 | 0 | – | – | – | – | – | – |
| Cell Periphery | 0 | 0 | 0 | 0 | 0 | 0 | 0 | – | 0 | 0 | 0 | 0 | – | – | 0 | 0 | 0 | 0 | 0 | 0 | 0 | 0 | 0 | 0 |
| Cytoplasm | 55 | 64 | 2 | 34 | 15 | 28 | 28 | – | 25 | 31 | 22 | 28 | – | – | 73 | 122 | 94 | 81 | 43 | 32 | 7 | 2 | 24 | 39 |
| Endoplasmic Reticulum | 1 | 0 | 0 | 0 | 1 | 0 | 0 | – | 1 | 0 | 2 | 1 | – | – | 0 | 15 | 6 | 7 | 0 | 0 | 0 | 0 | 0 | 0 |
| Endosome | 6 | 0 | 0 | 2 | 0 | 2 | 8 | – | 1 | 2 | 0 | 4 | – | – | 2 | 2 | 2 | 7 | 2 | 1 | 0 | 0 | 1 | 1 |
| Golgi | 0 | 0 | 0 | 0 | 1 | 0 | 0 | – | 0 | 0 | 0 | 0 | – | – | 1 | 2 | 2 | 0 | 0 | 0 | 0 | 0 | 0 | 0 |
| Mitochondria | 12 | 1 | 0 | 2 | 1 | 11 | 28 | – | 31 | 25 | 58 | 55 | – | – | 0 | 1 | 2 | 0 | 2 | 0 | 0 | 0 | 1 | 0 |
| Nucleus | 48 | 67 | 12 | 74 | 251 | 207 | 278 | – | 175 | 298 | 149 | 268 | – | – | 43 | 65 | 42 | 36 | 145 | 116 | 21 | 6 | 26 | 56 |
| Nuclear Periphery | 0 | 0 | 0 | 0 | 0 | 0 | 0 | – | 0 | 1 | 0 | 0 | – | – | 0 | 0 | 0 | 0 | 0 | 0 | 0 | 0 | 0 | 0 |
| Nucleolus | 0 | 0 | 0 | 0 | 0 | 0 | 0 | – | 2 | 1 | 3 | 0 | – | – | 0 | 0 | 0 | 2 | 0 | 1 | 0 | 0 | 0 | 0 |
| Peroxisomes | 0 | 0 | 0 | 0 | 0 | 0 | 0 | – | 0 | 0 | 1 | 0 | – | – | 0 | 0 | 0 | 0 | 0 | 0 | 0 | 0 | 0 | 0 |
| SpindlePole | 0 | 0 | 0 | 1 | 2 | 0 | 0 | – | 1 | 0 | 0 | 1 | – | – | 0 | 0 | 0 | 0 | 6 | 3 | 0 | 0 | 0 | 3 |
| Vac/Vac Membrane | 120 | 100 | 9 | 52 | 30 | 59 | 41 | – | 37 | 56 | 31 | 43 | – | – | 29 | 144 | 101 | 126 | 17 | 19 | 8 | 0 | 15 | 21 |
| Unique Cell Count | 192 | 173 | 17 | 146 | 281 | 284 | 356 | 247 | 389 | 220 | 353 | 136 | 267 | 200 | 213 | 225 | 188 | 42 | 13 | 79 | 139 | |||
| Labelled Cell Count | 242 | 232 | 23 | 165 | 301 | 307 | 385 | 275 | 416 | 270 | 404 | 148 | 351 | 250 | 259 | 225 | 188 | 42 | 13 | 79 | 139 | |||
Yeast GFP Assignment
Protein Abundance
| Screen | WT1 | WT2 | WT3 | RAP60 | RAP140 | RAP220 | RAP300 | RAP380 | RAP460 | RAP540 | RAP620 | RAP700 | HU80 | HU120 | HU160 | rpd3Δ_1 | rpd3Δ_2 | rpd3Δ_3 | AF100 | AF140 | AF180 |
|---|---|---|---|---|---|---|---|---|---|---|---|---|---|---|---|---|---|---|---|---|---|
| Mean Cell GFP Intensity (1e-4) | 5.7 | 7.6 | 6.6 | 6.8 | 7.8 | 6.5 | 6.5 | – | 6.1 | 6.1 | 5.5 | 5.8 | – | – | 7.4 | 11.1 | 11.0 | 10.1 | – | 7.0 | 7.3 |
| Std Deviation (1e-4) | 0.8 | 1.0 | 0.7 | 1.3 | 1.6 | 1.4 | 1.2 | – | 1.4 | 1.1 | 1.3 | 1.4 | – | – | 1.5 | 1.6 | 1.8 | 1.8 | – | 1.5 | 1.6 |
| Intensity Change (Log2) | – | – | – | 0.06 | 0.26 | -0.01 | -0.02 | – | -0.1 | -0.09 | -0.26 | -0.17 | – | – | 0.18 | 0.76 | 0.75 | 0.63 | – | 0.09 | 0.16 |
Localization Change
| Localization | RAP60 | RAP140 | RAP220 | RAP300 | RAP380 | RAP460 | RAP540 | RAP620 | RAP700 | HU80 | HU120 | HU160 | rpd3Δ_1 | rpd3Δ_2 | rpd3Δ_3 |
|---|---|---|---|---|---|---|---|---|---|---|---|---|---|---|---|
| Cortical Patches | 0 | 0 | 0 | 0 | – | 0 | 0 | 0 | 0 | – | – | 0 | 0 | 0 | 0 |
| Bud | 0 | 0 | 0 | 0 | – | 0 | 0 | 0 | 0 | – | – | 0 | 0 | 0 | 0 |
| Bud Neck | 0 | 0 | 0 | 0 | – | 0 | 0 | 0 | 0 | – | – | 0 | 0 | 0 | 0 |
| Bud Site | 0 | 0 | 0 | 0 | – | 0 | 0 | 0 | 0 | – | – | 0 | 0 | 0 | 0 |
| Cell Periphery | 0 | 0 | 0 | 0 | – | 0 | 0 | 0 | 0 | – | – | 0 | 0 | 0 | 0 |
| Cytoplasm | 0 | 0 | 0 | 0 | – | 0 | 0 | 0 | 0 | – | – | 3.3 | 2.7 | 2.8 | 2.2 |
| Endoplasmic Reticulum | 0 | 0 | 0 | 0 | – | 0 | 0 | 0 | 0 | – | – | 0 | 0 | 0 | 0 |
| Endosome | 0 | 0 | 0 | 0 | – | 0 | 0 | 0 | 0 | – | – | 0 | 0 | 0 | 0 |
| Golgi | 0 | 0 | 0 | 0 | – | 0 | 0 | 0 | 0 | – | – | 0 | 0 | 0 | 0 |
| Mitochondria | 0 | 0 | 0 | 0 | – | 0 | 0 | 0 | 0 | – | – | 0 | 0 | 0 | 0 |
| Nucleus | -1.6 | 2.3 | 0.2 | 0.7 | – | 0 | 0.6 | -0.2 | 0.5 | – | – | -3.2 | 0 | 0 | 0 |
| Nuclear Periphery | 0 | 0 | 0 | 0 | – | 0 | 0 | 0 | 0 | – | – | 0 | 0 | 0 | 0 |
| Nucleolus | 0 | 0 | 0 | 0 | – | 0 | 0 | 0 | 0 | – | – | 0 | 0 | 0 | 0 |
| Peroxisomes | 0 | 0 | 0 | 0 | – | 0 | 0 | 0 | 0 | – | – | 0 | 0 | 0 | 0 |
| SpindlePole | 0 | 0 | 0 | 0 | – | 0 | 0 | 0 | 0 | – | – | 0 | 0 | 0 | 0 |
| Vacuole | -1.4 | 0 | 0 | 0 | – | 0 | 0 | 0 | 0 | – | – | 0 | 0.1 | -0.2 | 0.5 |
External localization resources
Images






























Protein Concentration and Protein Localization Data
| R1 | R2 | R3 | ||||||||||||||||
|---|---|---|---|---|---|---|---|---|---|---|---|---|---|---|---|---|---|---|
| G1 Pre-START | G1 Post-START | S/G2 | Metaphase | Anaphase | Telophase | G1 Pre-START | G1 Post-START | S/G2 | Metaphase | Anaphase | Telophase | G1 Pre-START | G1 Post-START | S/G2 | Metaphase | Anaphase | Telophase | |
| Concentration | 2.3617 | 2.7346 | 2.6609 | 2.6139 | 1.4421 | 2.2719 | 1.8649 | 2.533 | 2.9406 | 2.3876 | 2.5064 | 2.5823 | 0.1101 | 0.6844 | 0.6926 | 0.593 | 0.7162 | 0.4761 |
| Actin | 0.0201 | 0.0003 | 0.0244 | 0.0135 | 0.01 | 0.0112 | 0.0313 | 0.0018 | 0.0062 | 0.0001 | 0.014 | 0.0009 | 0.0104 | 0.0003 | 0.0179 | 0.0275 | 0.0852 | 0.0004 |
| Bud | 0.0064 | 0.0042 | 0.0024 | 0.0091 | 0.0002 | 0.0033 | 0.001 | 0.0002 | 0.0008 | 0 | 0.0018 | 0.0002 | 0.0004 | 0.0007 | 0.0023 | 0.0002 | 0.0015 | 0.0002 |
| Bud Neck | 0.004 | 0.001 | 0.0017 | 0.0033 | 0.0009 | 0.0051 | 0.0076 | 0.0005 | 0.0032 | 0.0003 | 0.0007 | 0.002 | 0.0052 | 0.0004 | 0.001 | 0.0004 | 0.0013 | 0.0016 |
| Bud Periphery | 0.0043 | 0.0012 | 0.0028 | 0.0066 | 0.0003 | 0.001 | 0.0013 | 0.0001 | 0.0011 | 0 | 0.0036 | 0.0001 | 0.0003 | 0.0003 | 0.001 | 0.0002 | 0.0021 | 0.0001 |
| Bud Site | 0.0031 | 0.0032 | 0.0031 | 0.0027 | 0.0004 | 0.0007 | 0.0143 | 0.0018 | 0.0146 | 0.0002 | 0.0035 | 0.0002 | 0.0048 | 0.0014 | 0.0057 | 0.0007 | 0.0057 | 0.0004 |
| Cell Periphery | 0.0003 | 0.0001 | 0.0002 | 0.0003 | 0 | 0.0001 | 0.0003 | 0 | 0.0008 | 0 | 0.0001 | 0 | 0.0001 | 0.0001 | 0.0002 | 0 | 0.0003 | 0.0001 |
| Cytoplasm | 0.0927 | 0.1254 | 0.0468 | 0.0507 | 0.0695 | 0.0551 | 0.1629 | 0.2438 | 0.109 | 0.1056 | 0.1778 | 0.1142 | 0.2445 | 0.3472 | 0.1603 | 0.0885 | 0.1195 | 0.1116 |
| Cytoplasmic Foci | 0.0164 | 0.0041 | 0.0074 | 0.0132 | 0.0018 | 0.0029 | 0.0262 | 0.0018 | 0.014 | 0.0014 | 0.021 | 0.0033 | 0.0332 | 0.0021 | 0.0115 | 0.0153 | 0.0688 | 0.0027 |
| Eisosomes | 0.0002 | 0 | 0.0001 | 0.0001 | 0.0001 | 0.0001 | 0.0003 | 0 | 0.0001 | 0 | 0.0002 | 0 | 0.0001 | 0 | 0.0001 | 0.0001 | 0.0007 | 0 |
| Endoplasmic Reticulum | 0.0108 | 0.0021 | 0.0023 | 0.0018 | 0.0031 | 0.0013 | 0.0072 | 0.0015 | 0.0037 | 0.0007 | 0.0026 | 0.0012 | 0.0087 | 0.0042 | 0.0034 | 0.0008 | 0.0028 | 0.0053 |
| Endosome | 0.0354 | 0.0012 | 0.0076 | 0.0077 | 0.013 | 0.0044 | 0.0243 | 0.0014 | 0.0133 | 0.0008 | 0.0124 | 0.0028 | 0.0216 | 0.0018 | 0.0092 | 0.0171 | 0.0276 | 0.0232 |
| Golgi | 0.0096 | 0.0001 | 0.0031 | 0.0061 | 0.0026 | 0.0015 | 0.0084 | 0.0005 | 0.0045 | 0 | 0.0033 | 0.0013 | 0.0054 | 0 | 0.0065 | 0.0041 | 0.0105 | 0.0007 |
| Lipid Particles | 0.017 | 0.0001 | 0.0012 | 0.0083 | 0.0027 | 0.0064 | 0.017 | 0.0004 | 0.0071 | 0.0002 | 0.0122 | 0.0084 | 0.0136 | 0.0001 | 0.0054 | 0.0034 | 0.0061 | 0.0006 |
| Mitochondria | 0.0122 | 0.0005 | 0.011 | 0.0084 | 0.003 | 0.0055 | 0.0076 | 0.0038 | 0.008 | 0.0003 | 0.0098 | 0.0025 | 0.0058 | 0.0007 | 0.006 | 0.0013 | 0.0066 | 0.0007 |
| None | 0.0306 | 0.0369 | 0.0147 | 0.0265 | 0.0112 | 0.0262 | 0.0201 | 0.0147 | 0.0204 | 0.0749 | 0.0652 | 0.0021 | 0.0298 | 0.0202 | 0.0164 | 0.0393 | 0.0089 | 0.0228 |
| Nuclear Periphery | 0.0414 | 0.0144 | 0.0142 | 0.0082 | 0.0294 | 0.0159 | 0.0209 | 0.0104 | 0.0152 | 0.0066 | 0.012 | 0.0086 | 0.0378 | 0.0202 | 0.0196 | 0.0069 | 0.0121 | 0.0221 |
| Nucleolus | 0.0042 | 0.003 | 0.0021 | 0.0043 | 0.0082 | 0.0052 | 0.0016 | 0.0011 | 0.004 | 0.0009 | 0.0013 | 0.0016 | 0.0017 | 0.001 | 0.0014 | 0.0009 | 0.001 | 0.0009 |
| Nucleus | 0.6499 | 0.7787 | 0.8354 | 0.7951 | 0.776 | 0.8133 | 0.6204 | 0.7074 | 0.747 | 0.8041 | 0.6284 | 0.831 | 0.537 | 0.5749 | 0.7096 | 0.7842 | 0.6121 | 0.7966 |
| Peroxisomes | 0.0075 | 0.0001 | 0.0023 | 0.003 | 0.0006 | 0.0035 | 0.0126 | 0.0032 | 0.0161 | 0.0001 | 0.0179 | 0.0097 | 0.0082 | 0.0001 | 0.0077 | 0.0044 | 0.0097 | 0.0001 |
| Punctate Nuclear | 0.0249 | 0.021 | 0.0096 | 0.0266 | 0.0648 | 0.0348 | 0.0087 | 0.004 | 0.0064 | 0.0031 | 0.0105 | 0.0087 | 0.0234 | 0.0221 | 0.0058 | 0.0033 | 0.0148 | 0.005 |
| Vacuole | 0.0056 | 0.002 | 0.0063 | 0.003 | 0.001 | 0.0014 | 0.0047 | 0.0014 | 0.0036 | 0.0005 | 0.0013 | 0.0009 | 0.0062 | 0.002 | 0.0072 | 0.0009 | 0.0018 | 0.0039 |
| Vacuole Periphery | 0.0035 | 0.0003 | 0.0012 | 0.0014 | 0.0012 | 0.0012 | 0.0012 | 0.0002 | 0.0009 | 0.0001 | 0.0005 | 0.0002 | 0.0018 | 0.0004 | 0.0018 | 0.0003 | 0.001 | 0.001 |
Sequencing Data
| R1 | R2 | |||||||||
|---|---|---|---|---|---|---|---|---|---|---|
| G1 Post-START | S/G2 | Metaphase | Anaphase | Telophase | G1 Post-START | S/G2 | Metaphase | Anaphase | Telophase | |
| Gene Expression | 38.4176 | 19.142 | 9.1909 | 17.2857 | 42.8694 | 23.919 | 19.4968 | 14.7919 | 16.9466 | 32.4117 |
| Translational Efficiency | 0.7404 | 0.716 | 0.8352 | 0.7124 | 0.4197 | 0.9614 | 0.6446 | 0.4749 | 0.6208 | 0.6287 |
Hit Data
| Dataset | Hit |
|---|---|
| Protein Concentration | ✔ |
| Protein Localization | ✘ |
| Gene Expression | ✔ |
| Translational Efficiency | ✘ |
Endocytosis
| Temp | Actin Patch (Sac6-tdTomato) | Cortical Patch (Sla1-GFP) | Late Endosome (Snf7-GFP) | Vacuole (Vph1-GFP) |
|---|---|---|---|---|
| 37℃ | ||||
| RT |
Cell Cycle Omics
CYCLoPs (Rkm1-GFP)
| Gene / Allele | Actin Patch (Sac6-tdTomato) | Cortical Patch (Sla1-GFP) | Late Endosome (Snf7-GFP) | Vacuole (Sac6-tdTomato) |
|---|
| Gene | Images |
|---|
| Gene | Images |
|---|
Images are not yet available
Images are not yet available